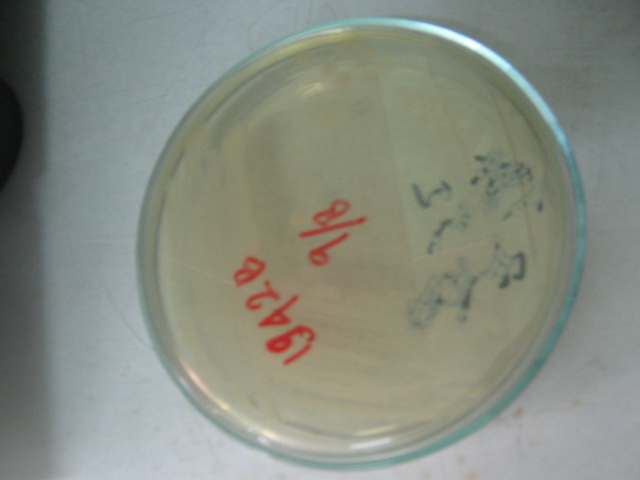

Cryptosporidium sp
Cryptoporidium sp menyebabkan penyakit Kriptosporodiosi.
Protozoa ini pertama kali ditemukan didalam lambung dan usus halus tikus oleh Tyzzer (1907). Semenjak itu Cryptoporidium sp telah diidentifikasi dari 170 spesies binatang, termasuk ayam, kalkun, babi, kuda, domba, anjing, tikus liar, burung, ikan, reptile. Dua laporan yang pertama mengenai infeksi pada manusia yaitu pada tahun 1976, yang menyerang anak berusia 3 tahun dengan keadaan immunocompetent dan orang dewasa dengan immunocompromised. Dari tahun 1976 sampai tahun 1982, kejadian infeksi pada manusia jarang dilaporkan. Pada tahun 1982 dalaporkan kejadian infeksi yang disebabkan meningkat drastic setelah diketahui criptosporodiosis infeksi opportunistic yang terjadi pada penderita AIDS.
Protozoa ini mempunyai siklus hidup yang kompleks melibatkan dari silus hidup seksual(Sporogoni) dan aseksual(Scyzogoni), tapi tidak memerlukan vector perantara ia mampu menyelesaikan siklus hidupnya dalam satu hospes. Ookista merupakan stadium infektif . Oosista keluar keluar dari tubuh hospes melalui feses.
Taksonomi
Kerajaan : Protista
Filum : Apicomplexia
Kelas : Sporozoasida
Ordo : Eucoccidiorida
Famili : Cryptosporidiidae
Genus : Cryptosporidium
Spesies : Cryptosporidium parvum (terdiri dari dua genotype,yaitu genotip 1 menyerang
Manusia,Serta Genotype 2 yang menyerang manusia,lembu dan mamalia lainya),
Cryptosporidium homnis (Pada manusia) Cryptosporidium baileyi (pada burung), Cryptosporidium felis (pada kucing),Cryptosporidium muris (pada ikan dan lembu), Cryptosporidium nasorum(pada ikan), Cryptosporidium serpentitis ( pada ular ),Cryptosporidium wrairi ( pada babi)
Ciri Morfologi
Cryptosporidium sp terdiri dari banyak spesiek tapi yang paling pathogen yaituCryptosporidium parvum yang menyebabkan diare kronis dan muntah
menyebabkan diare (kebanyakan kronis). Dalam siklus hidupnyaCryptosporidium sp mengalami beberapa kali perubahan bentuk (Stadium).
Berikut ini ciri morfologi :
-Sporozoit mempunyai bentuk seperti pisang dimana bagian anteriornya meruncing dan bagian posteriornya membulat.
-Gametosit dan skizon ukuran 2-4 mikro meter diproduksi dalam siklus hidupCryptosporidium parvum ,tapi jarang ditemukan pada feses manusia.
-Ookista Biasanya berbentuk bulat, berdiameter 4 - 6 um mengandung 4 sporozit yang tidak terlalu terlihat,refraktil, terdiri 1-8 granula yang menonjol dan dilapisi dua dinding tebal. Ookista resisten dan sangat resisten terhadap proses klorinasi tapi dapat mati dengan teknik pemasakan konvensional.
Distribusi Penyakit
Cryptosporidium sp tersebar diseluruh dunia(Kosmopolit). Ookista nyaditemukan pada spesimen tinja manusia di lebih dari 50 negara di enam benua. Di negara maju seperti AS dan Eropa, prevalensinya kurang dari 1 – 4.5 % dari hasil survei pemeriksaan tinja. Di negara berkembang, prevalensinya sangat tinggi berkisar antara 3 – 20 %. Anak-anak usia dibawah 2 tahun, mereka yang merawat binatang, pelancong, kaum homoseksual dan mereka yang kontak erat dengan orang-orang yang terinfeksi (keluarga, petugas kesehatan dan perawat di rumah penitipan anak) biasanya lebih mudah tertulari. KLB dilaporkan terjadi di tempat penitipan anak hampir diseluruh dunia. KLB juga di sebabkan oleh air minum yang tercemar (setidaknya 3 KLB besar yang pernah dilaporkan berkaitan dengan fasilitas air minum untuk umum); penularan dapat terjadi di tempat rekreasi yang menggunakan air seperti "waterslide", kolam renang dan danau; cuka apel yang tidak dipasturisasi yang terkontaminasi dengan kotoran sapi, pernah dilaporkan sebagai penyebab infeksi.
Cara Penularan
Infeksi penyakit ini dari bahan yang terkontaminasi seperti tanah, air, makanan yang tidak dimasak atau kontak dengan kotoran manusia atau hewan yang terinfeksi.Cara penularan melalui rute orofekal, yaitu penularan dari orang ke orang, dari binatang ke orang, melalui air dan penularan melalui makanan. Hal ini terutama terjadi diantara mereka yang biasa kontak dengan air tawar saat berenang. Tingginya resistensi oocysts Cryptosporidium terhadap disinfektan seperti khlor memungkinkan mereka untuk bertahan hidup dalam jangka waktu yang lama dan masih dalam kondisi siap menginfeksi Parasit menginfeksi sel epitel saluran pencernaan dan parasit memperbanyak diri mula-mula dengan cara schizogony, diikuti dengan siklus seksual dengan membentuk ookista dan dapat ditemukan pada tinja. Ookista dapat hidup di lingkungan yang jelek dalam waktu yang lama. Ookista sangat resisten terhadap desinfektan kimia yang digunakan untuk menjernihkan dan disinfeksi air minum. Sekali waktu siklus autoinfeksi bisa terjadi pada manusia.
Siklus Hidup
Ookista yang telah mengalami sporulasi, terdiri dari 4 sporozoit, dikeluarkan melalui feses organism yang terinfeksi dan mungkin mengalami rute yang lain seperti melalui sekresi saluran pernafasan (1). Transmisi dari Cryptosporidium parvum dan Cryptosporidium hominis umumnya terjadi melalui kontak dengan air yang telah terkontaminasi. Banyak wabah yang terjadi di Amerika Serikat terjadi di taman air, kolam renang, dan pusat pelayanan umum (2). Setelah tertelan(dan mungkin terhirup) oleh hospes (3) eksistasi terjadi (a). Empat sporozoit dikeluarkan dari tiap ookista,menembus epithelial (b,c) usus dan jaringan lain seperti saluran pernafasan. Sporozoid akan berkembang menjadi tropozoit. Kemudian mengalami multiplikasi aseksual (skizogoni atau merogoni) (d,e) yang menghasilkan meront tipe I. merozoit yang dihasilkan meron tipe satu dapat mereinfaksi sel dan mengulang kembali siklus asekseual atau menginfeksi sel dan berkembang menjadi meront tipe II (f). Tiap meron tipe II akan membesaskan 4 merozoit. Diyakini hanya merozoit tipe II inilahyang mengalami multiplikasi seksual (gametogoni) menghasilkan mikrogametosit(g) dan makrogametosit(h). Mikrogamet keluar dari mikrogametosit akan membuahi makrogamet yang keluar dari makrogametosit dan menghasilkan zigot (i). Sekitar 80% zigot akan berkembang menjadi ookista berdinding tebal (j) dan 20% zigot berkembang menjadi ookista berdinding tipis (k). Ookista akan bersporulasi (berkembang menjadi sporozoit yang infektif). Keluarnya sporozoit dari ookista yang berdinding tipis akan menyebabkan autoinfeksi. Sementara ookista berdinding tebal akan keluar melalui feses dan apabila tertelan akan segera menginfeksi.
Patogenesis
Cryptosporidium sp terutama pada spesies Cryptosporidium parvum(spesies yang paling patogen) menyebabkan cryptosporidiosis yaitu penyakit Zoonosis yang sering menimbulkan gangguan gastroenteritis. Penyakit ini ditularkan secara fekal oral. Berbagai jenis mamalia, unggas, reptile, ikan, dapat bertindak sebagai sumber infeksi.
Criptosporidium melekat padaa mikrovili usus halus atau hidup bebas pada kripta mukosa usus menyebabkan malabsorpsi dan diare akibat kerusakan bagian mukosa. Pada orang yang memiliki kekebalan tubuh penyakit tidak terlalu parah dan bisa sembuh sendiri kerena system imun dapat melawan infeksi. Sedangkan pada penderita penderita immunodefisiensi panyakit ini dapat menjadi parah karena sistem imunnya yang rusak.
Ketika Cryptosporidium menyebar ke luar usus karena penyakit ini dapat menjadi dominan akibat tubuh kekurangan imun pada pasien AIDS, mereka dapat mencapai paru-paru, telinga, pankreas, dan bagian perut lainnya. Parasit dapat menulari biliary tract (sekitar lever), menyebabkan biliary cryptosporidiosis. Hal ini menyebabkan cholecystitis dan cholangitis.
Pada usus :
Mekanisme cryptosporidiosis menyebabkan diare pada manusia belum spenuhnya dapat dimengerti. Namun danya kegagalan absorbsi dan meningkatkan sekresi usus halus banyak dijumpai pada kasusu-kasus tersebut.
Adhesi/invasi dari merozoit/sporozoit Cryptosporidium parvum kemembran apical dari sel epitel usus meransang sel epitel usus untuk memproduksiprostaglandin shyntase, IL-8, dan TNF-ά .Adanya sel polymerase (oleh IL-8), aktifasi makrofag (oleh TNF-ά),diproduksinya prostaglandin (olehprostaglandin shyntasei) dan perubahan fungsi ion diperkirakan merangsang sekresi usus untuk merespon infeksi seluler terhadap Cryptosporidium parvum.Infeksi seluler juga pendataran dan juga bersatunya villi usus, merupakan kemungkinan kedua yang terjadi pada infeksi sel dan atau dalam respon imunologi seluler. Gambaran ini berhubungan dengan malabsorpsi, dan akan memperberat diare. Sebagai tambahan, adanya proses-proses apoptosis sel-sel yang mati dan enteric nervous system juga member peranan terhadap patofisiologi diare ini.
Pada gambaran histopatologi menunjukan adanya atropi villi, hyperplasia krypta, dan infiltrasi ringan sampai sedang ( biasanya sel plasma atau netrofil tetapi dapat juga makrofag dan liphosit) pada lamina propria.
Pada Saluran Empedu
Walaupun gambaran klinis dan radiologi dari billiary cryptosporidiosi telah dapt diketahui, namun patogenitas sepenuhnya belum dapat sepenuhnya dimengerti. Gambaran histopatologi yang diperoleh dari biopsy ampulla vateri menunjukan menunjukan infiltrasi submukosa, inflamasi periductus dengan oedema interstisial, infiltrasi neutrofil dan hyperplasia/dilatasi kelenjar periduktus.
Pada Saluran Pernafasan
Patogenitas dari respiratory cryptosporidiosis juga masih belum dimengerti.respiratory cryptosporidiosis melibatkan trakea, bronkus, dan jarang melibatkan parenkim paru, dapat ditemukan pada penderita immunosuppressed dengan gagal nafas. Dari tahun 1983 sampai 1996 diperkirakan ada 13 kasusrespiratory cryptosporidiosis yang hanya melibatkan region tracheobroncial atas. Cryptosporidium sp yang dideteksi secara mikroskop diparenkim paru hanya dua kasus, satu kasus yang diderita oleh penderita AIDS dan penderita lain dengan acute nonlymphatic leukemia.
Diagnosis
Dalam kondisi normal, infeksi dengan parasit ini hanya menimbulkan gejala kriptosporidiosis yang ringan. Pada penderita imunokompeten keluhan dan gejala dapat berupa enteritis ringan, diare cair tidak lebih dari 10 kali sehari,dengan tinja tidak berdarah dan tidak berlendir. Umumnya penderita juga mengalami demam ringan, malaise, mual, mutah, kejang perut, dan berat badan menurun. Penyakit akan sembuh sendirinya dalam waktu 2-10 hari.
Pada penderita imunodefisiensi(misalnya penderita AIDS) yang terinfeksi dapat menyebabkan diare berat mirip diare kolera sebanyak sampai 70 kali seharidengan pengeluaran cairan lebih dari 10 liter per hari yang berlangsung berbulan-bulan. Penderita mengalami malabsorpsi berat, gangguan keseimbanagan cairan, berat badan menurun cepat dan terjadi limfadenopati. Pada immunodefisiensi demam jarang terjadi.
Untuk memperoleh diagnosis yang akurat perlu dilakukan pemeriksaan di laboratorium. Pemeriksaan mikroskopis pada tinja penderita menunjukkan adanya ookista parasit yang khas bentuknya. Pemeriksaan hitologis atas biopsi mukosa dengan menggunakan modifikasi ABF (Acid Fast Staining) atau pemeriksaan dengan menggunakan mikroskop fluoresen,menunjukan adanya parasit dalam jaringan . Deteksi dengan pewarnaan antibody monoclonal dapat memperkuat diagnosis. Pemeriksaan serologis misalnya dengan ELISA (Enzym Linked Immunosorbant assay), Immunofluorescens Antibody Technique(IFAT0 serta deteksi IgG dan IgM dalam membantu menetapkan diagnosis.
Terapi dan Pengobatan
Tidak ada obat yang bisa diandalkan untuk pengobatan radang usus cryptosporidium. Obat tertentu seperti paromomycin, atovaquone, nitazoxanide, dan azithromycin kadang-kadang digunakan, tetapi biasanya hanya memiliki efek sementara. Kesulitan ini terutama terjadi untuk orang dengan penyakit parah dan sistem kekebalan yang lemah.
Pengobatan bisa manjur pada tahap awal penyakit. Cairan-cairan perlu terus diganti secara oral (banyak minum). Dalam situasi langka, cairan darah mungkin diperlukan. Antibiotik biasanya tidak bermanfaat, dan kekambuhan ulang sering terjadi.
Pada immunokompeten (imun sehat)
Mayoritas individu dengan immuno-kompeten mengalami penyakit ini dalam waktu singkat (kurang dari 2 minggu) yang membutuhkan perawatan dengan pencegahan pada dehidrasi yaitu banyak minum air dan kadang-kadang menggunakan obat anti-diarrhoeal. Nitazoxanide adalah salah satu obat yang telah disetujui FDA (badan obat-obatan USA) untuk digunakan pada orang dengan immunocompetent untuk memerangi diare. Spiramycin dapat membantu memperpendek lama diare pada anak-anak.
Pada immunocompromised (imun rendah)
Pada immunocompromised seperti pengidap AIDS, penyembuhan penyakit cryptosporidiosis berjalan lambat atau bisa juga tidak dapat disembuhkan sama sekali. Sering menyebabkan kondisi parah dan permanen terutama dalam bentuk diare berair yang digabungkan dengan menurunnya kemampuan usus untuk menyerap gizi. Hasilnya adalah penyakit akan semakin parah : dehidrasi, ketidakseimbangan elektrolit, kekurangan gizi, kekurangan tenaga, dan akhirnya mati. Spiramycin dapat membantu dalam merawat pasien diare yang sedang dalam tahap awal AIDS.
Tingkat kematian bagi pasien yang terinfeksi AIDS pada umumnya didasarkan pada jumlah CD4; pasien dengan CD4 lebih dari 180 sel / mm ³ umumnya sembuh dengan dukungan dan perawatan dari obat rumah sakit, tetapi pasien dengan CD4 di bawah 50 sel / mm ³, efeknya biasanya fatal dalam tiga sampai enam bulan. Kasus (langka) : seorang pasien AIDS dari Iran yang telah mengalami pulmonary cryptosporidiosis selain cryptosporidiosis usus, pemberian azithromycin dan paromomycin membantu menghapus infeksi dari tubuhnya.
Saat ini, pendekatan yang terbaik adalah bagaimana meningkatkan status kekebalan pada pasien dengan immunodefisiensi. Probiotic Saccharomyces boulardii dijual melalui apotik-apotik dan toko-toko kesehatan (dengan nama merek obat Florastor di Amerika Serikat dan DiarSafe di Inggris) telah ditemukan untuk menjadi bermanfaat dalam perawatan diare dan gejala penyakit lainnya termasuk cryptosporidium. Parenteral octreotide asetat dapat membantu menurunkan jumlah kotoran yang keluar.
Cara -Cara Pemberantasan.
1.Cara pencegahan:
-Berikan penyuluhan kepada masyarakat tentang cara-cara menjaga kebersihan perorangan.
-Membuang tinja pada jamban yang saniter, hati-hati dalam menangani kotoran manusia atau binatang.
-Mereka yang kontak dengan anak sapi atau binatang lain yang terkena diare sebaiknya segera mencuci tangan dengan seksama.
-Rebus sampai mendidih air minum selama 1 menit; disinfeksi dengan bahan kimia tidak efektif melawan oocyst. Hanya filter yang dapat menyaring partikel dengan diameter 0,1 – 1 µm yang bisa di gunakan untuk menyaring oocyst.
-Pindahkan orang yang terinfeksi dari pekerjaan menangani jenis bahan makanan yang tidak segera akan dimasak.
-Pisahkan anak yang menderita diare dari tempat penitipan anak hingga diare sembuh.
2.Pengawasan penderita, kontak dan lingkungan sekitar.
-Laporan kepada instansi kesehatan setempat; kasus dilaporkan ke instansi kesehatan setempat dengan cara yang paling praktis, kelas 3B (lihat tentang pelaporan penyakit menular).
-Isolasi : bagi penderita yang dirawat di Rumah Sakit, lakukan tindakan kewaspadaan enterik dalam menangani tinja, begitu juga terhadap muntahan dan sprei serta sarung bantal dan baju yang terkontaminasi; orang yang terinfeksi tidak diijinkan menangani makanan dan merawat pasien yang dirawat di Rumah Sakit dan tidak diperkenankan merawat pasien yang dirawat di tempat spesifik; penderita asimptomatik yang bekerja pada bidang pekerjaan yang sensitif tidak diijinkan lagi bekerja sampai mereka sembuh. Tekankan tentang pentingnya kebiasaan mencuci tangan dengan benar.
-Disinfeksi serentak: dilakukan terhadap tinja dan barang-barang yang terkontaminasi dengan tinja. Pada masyarakat modern dengan sistem jamban saniter, tinja dapat dibuang langsung ke saluran pembuangan tanpa perlu di disinfeksi. Lakukan pembersihan terminal. Disinfeksi dapat dilakukan dengan pemanasan hingga 450 C (1130F) selama 5 – 20 menit, 600 C (1400 F) selama 2 menit atau disinfeksi kimia dengan 10 % cairan formalin atau 5 % ammonia, cara-cara tersebut cukup efektif.
-Investigasi kontak atau sumber infeksi: Lakukan pemeriksaan mikroskopis terhadap tinja anggota rumah tangga dan kontak lain yang dicurigai, terutama orang-orang tanpa gejala. Terhadap mereka yang kontak dengan hewan ternak dan binatang peliharaan diharuskan juga untuk dilakukan pemeriksaan. Jika dicurigai penularan terjadi melalui air, penyaringan air dalam jumlah sampel yang besar dapat dilakukan untuk melihat adanya oocyst pada air.
-Pengobatan spesifik : Tidak ada pengobatan spesifik untk kriptosoridiosis selain rehidrasi, jika diperlukan, rehidrasi telah terbukti efektif; pemberian antibodi pasif dan antibiotik saat ini sedang dalam penelitian. Mereka yang dalam pengobatan dengan obat imunosupresif, sebaiknya menghentikan pengobatan itu untuk sementara atau mengurangi dosisnya jika memungkinkan.
3.Penanggulangan wabah
Untuk menanggulangi wabah perlu dilakukan Investigasi epidemiologis terhadap kasus yang berkelompok yang terjadi pada suatu daerah atau institusi tertentu untuk mengetahui sumber infeksi dan cara-cara penularannya; selidiki kemungkinan sumber penularan "Common source", seperti sarana rekreasi air, air minum, susu mentah atau makanan atau minuman yang potensial tercemar dan lakukan upaya pencegahan dan pemberantasan yang mudah di terapkan. Upaya untuk mencegah penularan dari orang ke orang atau dari binatang ke manusia menekankan pada upaya kebersihan perorangan dan pembuangan tinja yang saniter.
:santovi
Protozoa ini pertama kali ditemukan didalam lambung dan usus halus tikus oleh Tyzzer (1907). Semenjak itu Cryptoporidium sp telah diidentifikasi dari 170 spesies binatang, termasuk ayam, kalkun, babi, kuda, domba, anjing, tikus liar, burung, ikan, reptile. Dua laporan yang pertama mengenai infeksi pada manusia yaitu pada tahun 1976, yang menyerang anak berusia 3 tahun dengan keadaan immunocompetent dan orang dewasa dengan immunocompromised. Dari tahun 1976 sampai tahun 1982, kejadian infeksi pada manusia jarang dilaporkan. Pada tahun 1982 dalaporkan kejadian infeksi yang disebabkan meningkat drastic setelah diketahui criptosporodiosis infeksi opportunistic yang terjadi pada penderita AIDS.
Filum : Apicomplexia
Kelas : Sporozoasida
Ordo : Eucoccidiorida
Famili : Cryptosporidiidae
Genus : Cryptosporidium
menyebabkan diare (kebanyakan kronis). Dalam siklus hidupnyaCryptosporidium sp mengalami beberapa kali perubahan bentuk (Stadium).
Distribusi Penyakit













 Kegunaan : Untuk isolasi dan pertumbuhan berbagai macam mikroorganisme,terutama
Kegunaan : Untuk isolasi dan pertumbuhan berbagai macam mikroorganisme,terutama